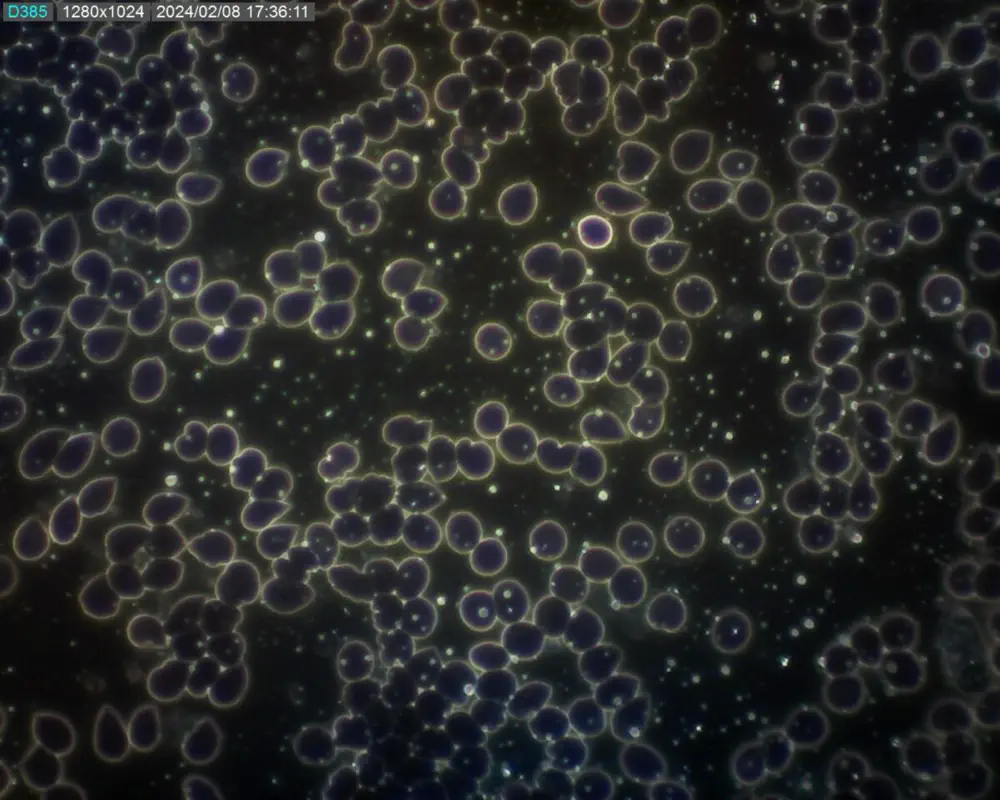
Kapka krve
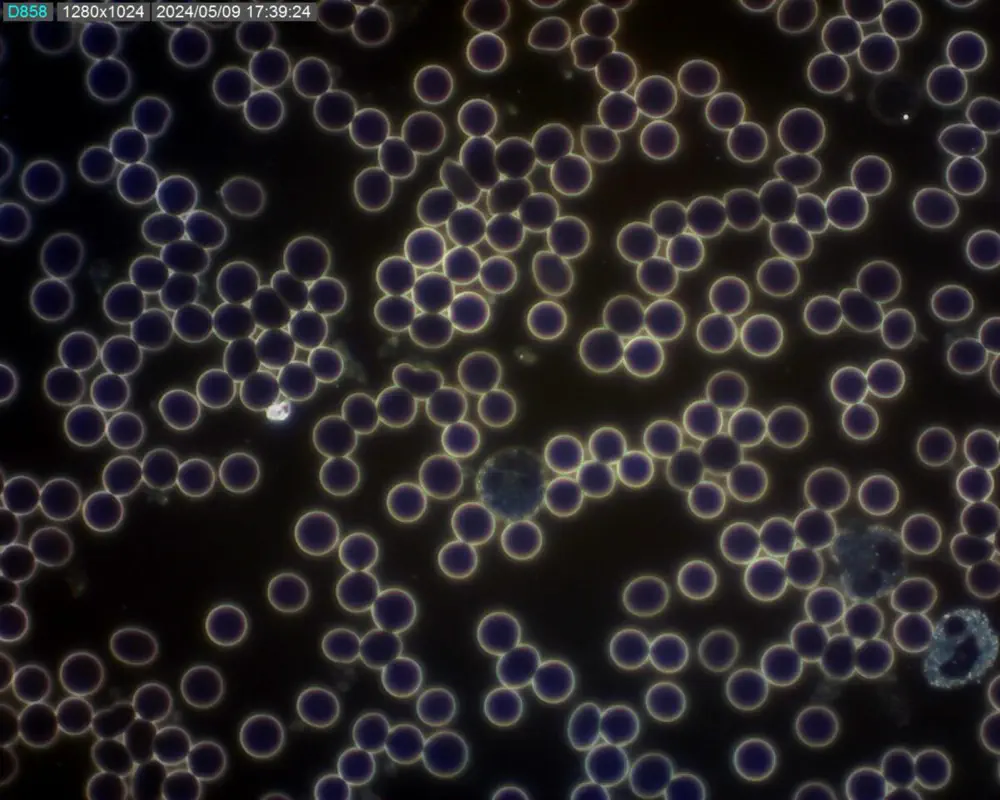
Kapka krve

Histaminová intolerance očima psychosomatiky
Dovolím si se svolením mé klientky Aničky zveřejnit její příběh a jeho psychosomatické řešení u nás v KP Clinic. Anička, které je 24 let, mě navštívila 10.1.2024, měla potvrzenou histaminovou intoleranci od lékaře. Trpěla velkými úzkostmi.

Histaminová intolerance má mnohdy příčinu v emoční nerovnováze a těžce se jí člověk zbavuje, pokud nevyřeší své JÁ.
Něco málo o Aničce – je jedináček, rodiče měli vysoké nároky na výkon a přáli si, aby šla v jejich šlépějích i pracovně. To si přeje mnoho rodičů, akorát to nesouznělo s jejími představami. Nedokázala jim to sdělit a začala se velmi trápit. Energeticky se necítila v pohodě, v těle se usídlilo napětí, aby to vše zvládla podle jejich představ. To ji rozhodilo celé trávení. Tělo začalo bojovat samo se sebou. Začaly jsme práci s psychikou, provedly jsme spolu speciální terapie na uvolnění strachů, nastolení rovnováhy a začaly jsme pracovat na změně mysli, aktivní komunikace, řešily jsme rodové programy.
Velmi se jí ulevilo. Následně jsme se podívaly na kapku krve, kde bylo zjevné poškození krevních buněk díky stálému stresu.
Krvinky ztrácely tvar, deformovaly se. Díky tomu byl velmi oslabený imunitní systém. Bílé krvinky začaly produkovat velké množství histaminu na svou obranu. Začalo se to projevovat špatným trávením, až ekzémy na kůži. Bylo potřeba provést řízenou detoxikaci a tím nastolit stabilizaci imunitních reakcí. Toto jsme provedly jak kvalitními produkty, tak pomocí frekvenčního přístroje BICOM optima, který dokáže vyladit energetiku těla až na úrovni buněk. Ladily jsme tělo i psychiku současně. Kontrola proběhla 8.2.2024, kde je vidět rozvolnění krvinek a řízená detoxikace.
Anička se cítila lépe. Byla velmi pečlivá a vzorná klientka.
Poslední kontrola proběhla 9.5.2024, kde můžete sami vidět, jak došlo k ozdravení její kapky krve, zesílení bílých krvinek a hlavně zklidnění psychiky. Červené krvinky jsou pevné, kulaté. Už se nedeformují. Absolvovala i celodenní seminář, kde si ujasnila, jakou cestou se chce vydat ve svém životě.
Co říci na závěr. Během 5 měsíců se zbavila všech svých potíží, změnila pohled na život, vymezila si životní hranice. Je to možné, jen je potřeba na člověka nahlížet jako na celek. Zdraví řídí energie v našich buňkách. Množství energie, která se dopraví do buněk ovlivňuje péče o tělo a hlavně naše mysl…

